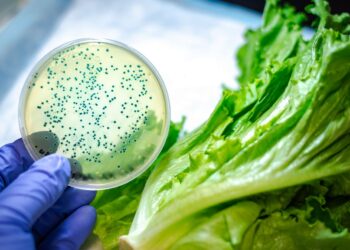

Innovative antibacterial treatment for metal surfaces
Researchers at Pudrue University developed an antimicrobial peptide-based treatment for metal surfaces that targets the bacterial population The focus on cleanliness and sanitation today is a hotter topic than ever ...